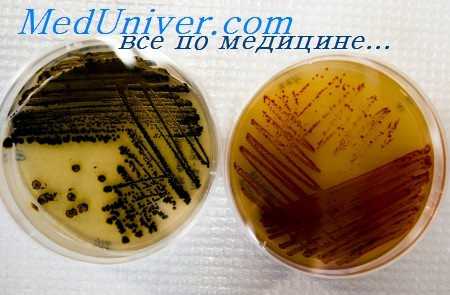
антибиотик

Концентрация антибиотика. Механизмы взаимодействия антибиотиков
Добавил пользователь Евгений Кузнецов Обновлено: 03.12.2025
Здесь мы рассмотрим один из сложнейших моментов в использовании антибактериальных препаратов, а именно поговорим об их фармакокинетических и фармакодинамических особенностях.
Материалы предназначены исключительно для врачей и специалистов с высшим медицинским образованием. Статьи носят информационно-образовательный характер. Самолечение и самодиагностика крайне опасны для здоровья. Автор статей не дает медицинских консультаций: клинический фармаколог — это врач только и исключительно для врачей.
Автор: Трубачева Е.С., врач – клинический фармаколог
Мы уже говорили, как работают лекарства в целом и как нужно их дозировать. Сегодня же мы поднимем один из сложнейших моментов в использовании антибактериальных препаратов, а именно поговорим об их фармакокинетических и фармакодинамических особенностях.
Если не вдаваться в сложные определения, то фармакокинетика – это то, что организм делает с лекарством, а именно всасывает, распределяет и выводит, а фармакодинамика – это то, что лекарство делает с организмом, т.е. реализует свои терапевтические эффекты.
Когда мы говорим об антибактериальных препаратах, то под фармакодинамическими эффектами мы будем понимать токсический эффект и антибактериальный эффект в очаге инфекции. Выраженность антибактериального действия в очаге инфекции определяется фармакокинетикой препаратов и особенностями их взаимодействия с микробами при различных концентрациях. Предполагается, что количество микроорганизмов в очаге инфекции в каждый момент времени определяется соотношением концентрации антибиотика и уровнем его антимикробной активности в этой концентрации (Сидоренко С.В.)
Антибактериальные эффекты проявляются в разных вариантах:
1. Полное подавление видимого роста – это один из возможных вариантов и с ним все понятно
2. Действие на микроб субингибирующий концентраций, то есть концентраций меньших, чем МПК (минимальная подавляющая концентрация). Дело в том, что при действии этих концентраций в микробной клетке изменяется распределение энергии и она начинает тратиться на компенсацию частично угнетенных функций и уменьшается количество энергии на обеспечение жизненно-важных функций клетки и проявляется это множеством эффектов, самые показательные из которых – снижение скорости роста и уменьшение биомассы культуры в стационарной фазе роста.
Что это нам дает в практическом плане? Важнейшим эффектом субингибирующих доз антибиотиков является нарушение синтеза внешней мембраны, что проявляется в изменении морфологии микроба, (т.е. появляются овоидные, филаментные и другие формы) и снижается уровень продукции факторов вирулентности (адгезинов, факторов инвазии, токсинов и т.п.). Все эти изменения приводят к повышению чувствительности микробов к гуморальными клеточным бактерицидным факторам, а также резко снижают адгезивную способность микроорганизмов.
3. Часть антибиотиков проявляет в отношении на микробов бактерицидное действие, при концентрациях превышающих МПК. Выраженность бактерицидного действия характеризуется величиной МБК (минимальной бактерицидной концентрацией) – это концентрация, обеспечивающая отмирание 99,99% микробной популяции в течение периода наблюдения (чаще всего 8 – 12 часов).
Здесь антибиотики можно разделить на 2 группы:
a) Антибиотики, у которых бактерицидный эффект зависит от концентрации, т.е. скорость отмирания микроорганизмов под действием антибиотика прямо пропорциональна концентрации этого самого антибиотика. Сюда относятся фторхинолоны, аминогликозиды, метронидазол и азитромицин
b) Антибиотики, чей бактерицидный эффект зависит от времени. Превышение их концентрации выше определенного уровня не сопровождается усилением бактерицидного эффекта. Сюда относятся все бета-лактамы, макролиды, кроме азиромицина, линкозамиды и гликопептиды. (не пугаемся, в дальнейшем я объясню все это подробнее)
4. Кроме того имеются еще и персистирующие эффекты, самым известным из которых является постантибиотический эффект (ПАЭ), определенный как время задержки пролифирации микроорганизмов после их обработки антибиотиком как в ингибирующих, так и в субингибирующих концентрациях. Чтобы было понятно – возьмем 2 чашки с посеянными микробами, одну из которых обработаем антибиотиком, а потом каким-то образом удалим этот антибиотик – по сравнению с необработанной чашкой, рост в обработанной начнется заметно позже – это и есть постантибиотический эффект.
Он важен с практической точки зрения тем, что микроорганизмы, обработанные антибиотиком более чувствительны к бактерицидному действию фагоцитов.
Для чего мы сейчас во все это вникали и через все это продирались? Дело в том, что в процессе химиотерпаии происходит смена всех вариантов взаимодействия между микробом и антибиотиком (рисунок 1).

На стадии всасывания и распределения лекарственного вещества на микроб последовательно действуют субингибирующая, ингибирующая и бактерицидная концентрации. В период выведения последовательность становится обратной – бактерицидная, ингибирующая, субингибирующая и, если есть, постантибиотический эффект, т.е. после полного выведения антибиотика микробы не размножаются в период его действия.
Мы помним, что, за очень редким исключением, после однократного введения обеспечить эрадикацию всех микробов в организме невозможно, так как микробы могут находиться в биопленках, да и вообще они довольно социальные существа и у них есть пул клеток, которые находятся как бы в споре и не размножаются, а тихо спят, пока все остальные ведут веселую общественную жизнь, но как только популяция начинает гибнуть, тут же оживают и восстанавливают ее в том же объеме (эта гипотеза недавно получившая экспериментальное подтверждение). Так что антибактериальная терапия должна быть курсовой. А вот длительность этого курса определяется эмпирически, но об этом мы поговорим в другой раз.
Концентрация антибиотика. Механизмы взаимодействия антибиотиков
Выбор пути введения антибиотика. Свойства антибиотика учитываемые при выборе
В целом предпочтительнее пероральный путь введения. Парентеральная терапия необходима в тех случаях, когда у пациента плохо функционирует пищеварительный тракт, снижено кровяное давление, требуется сразу же создать терапевтическую концентрацию антибиотика в организме (например, при угрожающих жизни инфекциях) или при пероральном приеме антибиотик не всасывается в количествах, достаточных для создания терапевтической концентрации в очаге инфекции. Местное применение антибиотиков показано при некоторых местных инфекциях (например, бактериальном конъюнктивите).
Перед выбором антибиотика необходимо принять во внимание ряд важных факторов. К числу этих факторов относятся следующие:
• активность по отношению к патогену(-ам), но эта информация может отсутствовать на момент, когда необходимо начать лечение;
• способность достичь очага инфекции в терапевтической концентрации. Для этого следует знать, должен ли антибиотик обладать бактерио-статическими или бактерицидными свойствами в отношении известного или подозреваемого патогена, т.к. при определенных инфекциях необходимо исключительно бактерицидное действие;
• доступные пути введения для конкретного пациента;
• профиль побочных эффектов, их влияние на имеющееся заболевание и возможное лекарственное взаимодействие;
• частота применения лекарства, что имеет особое значение для амбулаторных пациентов, для которых введение препарата более 1-2 раз в день может создавать трудности;
• при использовании антибиотика в жидком виде (преимущественно для маленьких детей) следует выяснить, приемлем ли он на вкус и в какой степени он стабилен при разных температурах. Суспензии некоторых антибиотиков для сохранности следует держать в холодильнике;
• стоимость лечения; речь об истинной стоимости лечения, в которую входят цена препарата, плата за введение, мониторинг и осложнения, в том числе отсутствие эффекта лечения и стоимость повторной терапии.
Далее будет рассмотрены основные классы антибиотиков, а также другие антибиотики, которые трудно классифицировать.
Различают следующие классы антибиотиков:
• ингибиторы синтеза клеточной стенки бактерий;
• ингибиторы функций мембран бактериальной клетки;
• ингибиторы синтеза бактериальной ДНК;
• ингибиторы синтеза бактериальной РНК;
• трудно классифицируемые антибиотики (смешанный класс);
• антибиотики местного применения;
• антибиотики для лечения микобактериальных инфекций.
Далее описан каждый класс и некоторые из составляющих его антибиотики. После обсуждения химической природы каждого класса приведены сведения о фармакологии в плане механизмов антибактериального действия, спектра активности, а также других фармакологических эффектов. Проанализированы терапевтическое применение антибиотиков, фармакокинетические характеристики, побочные эффекты и токсичность.
Информация на сайте подлежит консультации лечащим врачом и не заменяет очной консультации с ним.
См. подробнее в пользовательском соглашении.
Спектр действия антибиотика. Резистентность к антибиотику
Выбор антибиотика основан на механизме его действия, эффективности, токсичности и фармакокинетических свойствах. Последние приведены в таблицах, помещенных в тексте после описания отдельных классов антибиотиков. Каждый антибиотик имеет собственный путь введения и фармакокинетические характеристики, помогающие определить применимость антибиотика в каждом конкретном случае.
Резистентность к антибиотику
Антибиотик может иметь широкий или узкий спектр действия против бактерий различных видов. Антибиотики, активные против бактерий многих видов, называют антибиотиками широкого спектра действия. Антибиотики, которые активны лишь против некоторых видов, относят к антибиотикам узкого спектра действия. Однако такое деление до некоторой степени условно.
Резистентность к антибиотикам бывает естественной (врожденной) или приобретенной. Естественная резистентность бактерий к антибиотику является их изначальным свойством и основана на механизме действия или других характеристиках антибиотика. Например, у анаэробных бактерий отсутствует механизм кислородозависимого транспорта, необходимого для транспортировки аминогликозидов в бактериальную клетку, поэтому анаэробы обладают естественной резистентностью к аминогликозидам.
С другой стороны, приобретенная резистентность относится к приобретению гена, придающего это качество бактериям, не обладающим естественной резистентностью. Здесь антибиотик выполняет роль фактора, оказывающего избирательное эволюционное давление на бактерии, у которых развивается резистентность, чтобы обеспечить их выживаемость. Однако вероятность развития специфической резистентности зависит как от антибиотика, так и от самих бактерий.

В некоторых случаях для возникновения клинически значимой резистентности достаточно лишь одиночной мутации в бактериальном геноме. В других случаях для приобретения фенотипа резистентности необходимы множественные мутации.
Известны три основных биохимических механизма приобретенной резистентности:
• снижение проницаемости бактерий по отношению к антибиотику вследствие изменений клеточной мембраны у грамотрицательных бактерий;
• продукция бактериальных ферментов, изменяющих молекулярную структуру антибиотика. Эти ферменты могут быть гидролитическими (например, Р-лактамазы) или негидролитическими (например, ферменты, модифицирующие аминогликозиды);
• изменение мишени для антибиотика в результате одиночной мутации гена, кодирующего участок, связывающий антибиотик, может быть достаточным для возникновения клинически значимой резистентности (например, у Staphylococcus aureus, резистентных к метициллину, MRSA).
Существуют значительные различия структуры клеточной стенки и клеточной мембраны у грамположительных и грамотрицательных бактерий. Грамположительные бактерии содержат наружную клеточную стенку, состоящую из многих слоев пептидогликана, под которой находится клеточная мембрана. Эти слои пептидогликана не являются существенным препятствием для проникновения антибиотиков. Грамотрицательные бактерии обладают наружной клеточной мембраной, содержащей большое количество липополисахарида, а также истинной внутренней цитоплазматической мембраной.
Последняя покрыта меньшим, чем у грамположительных бактерий, числом полигликановых слоев и отделена от наружной мембраны периплазматическим пространством. Наружная мембрана состоит из фосфолипидного бислоя, пронизанного водными каналами, образованными белками наружной мембраны, которые называют поринами. Таким образом, грамотрицательные бактерии обладают серьезным барьером на пути проникновения лекарств. Липофильные препараты или водорастворимые вещества с низкой молекулярной массой могут проходить через пориновые каналы. Изменения содержания или состава пориновых белков или липополисахаридов наружной мембраны могут обусловить возникновение резистентности вследствие снижения проницаемости к антибиотикам. Мутации, в результате которых уменьшается проницаемость мембраны бактериальной клетки по отношению к одному антибиотику, часто сопровождаются снижением проницаемости к другим антибиотикам, вследствие этого развивается полимедикаментозная резистентность.
Подавление роста бактерий и их гибель зависят от концентрации антибиотика. Активность конкретного антибиотика против определенных бактерий можно легко определить в лаборатории. Подвергая стандартное число бактерий (инокулюм) воздействию антибиотика, взятого в различных концентрациях, определяют наименьшую из них, которая ингибирует рост бактерий. Эту концентрацию называют минимальной ингибирующей концентрацией (МИК). Если увеличивать концентрацию сверх МИК, то обычно достигают такой концентрации, которая убивает бактерии (термин «убивает» означает, что число живых бактерий в инокулюме снижается в 1000 раз [log103,0], или на 99,9%).
Наименьшую концентрацию антибиотика, необходимую для того, чтобы убить бактерии, называют минимальной бактерицидной концентрацией (МБК). Как правило, МБК в 2-8 раз выше, чем МИК. Антибиотики, для которых в клинических условиях удается достичь концентрации в крови, превышающей МБК в отношении обычных патогенов, классифицируют как бактерицидные антибиотики. Антибиотики, для которых легко достижимы концентрации выше МИК, но обычно не превышающие МБК, называют бактериостатическими антибиотиками. Однако нельзя отнести антибиотик к преимущественно бактериостатическим или бактерицидным, поскольку существует уникальное соотношение между каждой бактерией и каждым антибиотиком.
Например, пенициллин, который считают классическим бактерицидным антибиотиком, почти всегда бактерициден для стрептококков, однако оказывает лишь бактериостатическое действие на энтерококки. Похожим образом хлорамфеникол является бактериостатическим препаратом против большинства видов кишечных бактерий, но оказывает бактерицидный эффект на большинство штаммов Haemophilus influenzae.

Механизмы взаимодействия антибиотиков
Антибиотики могут действовать синергично, антагонистически или индифферентно. Иногда для лечения заболевания, вызванного определенным патогеном, используют комбинацию двух или более антибиотиков. С помощью лабораторных методов можно охарактеризовать отношение антибактериального действия двух (или более) антибиотиков на определенные бактерии как си-нергичное, антагонистическое или индифферентное, сопоставляя эффекты комбинации антибиотиков и каждого из них в отдельности на рост бактерий:
• если комбинация препаратов заметно повышает антибактериальный эффект (выше, чем наиболее активный агент), комбинацию называют синергичной, т.е. общий эффект выше аддитивного;
• если в результате применения комбинации подавление бактериального роста оказывается слабее, чем вызываемое наиболее активным агентом в отдельности, такая комбинация является антагонистической;
• если комбинация не дает ни синергичного, ни антагонистического эффектов, она является индифферентной. На практике большинство комбинаций относятся к индифферентным. Однако в клинике выявлены важные синергичные и анагонистические комбинации:
• процент успешного лечения энтерококкового эндокардита с помощью комбинации пенициллин плюс аминогликозид существенно выше, чем при использовании одного пенициллина, что свидетельствует о наличии синергизма;
• комбинация пенициллина и тетрациклина для лечения бактериального менингита ассоциируется со значительно более высокой смертностью, чем в случае применения одного пенициллина — пример антагонизма.
Эта глава направлена на то, чтобы в дальнейшем мы могли говорить на одном языке и понимать друг друга.
Итак, «Азбука Антибиотиков». Почему «Азбука»? Потому что любое новое направление изучения чего-либо должно начинаться с самых азов. Публикаций по антибактериальной терапии великое множество, книг не меньше, только есть одна маленькая загвоздка – все они предназначены, что называется, для продвинутого пользователя. Вопрос в том, как этим продвинутым стать. Мы решили попытаться решить эту задачу, и поэтому данный цикл не будет содержать ни науки, ни даже наукообразия. Здесь в максимально доступной, а где-то даже в просторечной форме, просто об очень сложном, будет публиковаться материал, без которого постижение антибактериальной терапии становится очень трудоемкой и времязатратной задачей, а то и вовсе вырождается в тоску зеленую. Вот эту самую трудность мы и попытаемся снять, чтобы в дальнейшем было легко ориентироваться в том, что написано для продвинутых пользователей.
Почему «Антибиотиков»? Безусловно, правильно говорить «антимикробный препарат» и «антимикробная терапия». Во-первых, потому что антибиотик – это «антижизнь», и тогда куда девать бактериостатики, которые лишь подавляют размножение? В микробиологические контрацептивы относить? Во-вторых, истинные антибиотики – это то, что природа сама насинтезировала в процессе эволюции в течение даже не веков, а тысячелетий – пенициллин, например. Думать о том, что микромир примитивен – это крайне наивное заблуждение. У микробов формируются целые сообщества (классический пример – биопленка), внутри которых ведется бурная социальная, да, я не оговорилась, именно социальная жизнь. Члены сообщества обмениваются информацией, осуществляют горизонтальный перенос факторов устойчивости, кого-то геноцидят, а кого-то холят и лелеют, как своеобразный back up, на случай гибели популяции. Кроме того, там постоянно ведется борьба за «место под солнцем», и одни популяции тиранят другие, вплоть до межвидовых сражений на уничтожение одних другими. А чем удобнее всего сражаться? Правильно – применением антибиотиков. Или подавлять размножение ненужной популяции в рамках одного сообщества бактериостатиками – именно по этому принципу дикие формы уничтожают антибиотикорезистентные – вторые банально не выдерживают накала внутривидовой борьбы. Все остальное, людьми сочиненное и синтезированное – это антимикробные препараты, перекрывающие весь возможный на данный момент спектр возбудителей и обладающие как бактерицидным, так и бактериостатическим действием. Но как дань традиции и, скажем честно, просто привычке, в медицинской среде всю антимикробную терапию привычно обзывают антибиотиками, и кто мы такие, чтобы эту самую традицию менять. Поэтому все, что будет написано далее, будет называться антибиотиками и антибиотикотерапией (АБТ), подразумевая под собой исключительно антимикробность существующего.
Как будет строиться наш цикл? Во-первых, от простого к более сложному, во-вторых, по алфавиту, для простоты навигации. И сегодня мы поговорим о первой букве алфавита А – «азах».
А – «Азы»
Эта глава направлена на то, чтобы в дальнейшем мы могли говорить на одном языке и понимать друг друга. Что-то объяснено подробно, а что-то пока надо принять за аксиому, так как объяснения займут объем, намного превосходящий данную статью. Мы поговорим и об этом, но чуть позже.
1. С какими возбудителями инфекций мы имеем дело в повседневной практике?
В 95% случаев это будет дикая, непуганая микрофлора, ни разу не встретившая на своем пути сделанный человечеством антибиотик. Таких возбудителей мы будем называть дикими (пару раз в литературе встречалось название «наивные», но оно не прижилось, ибо где, например Yersinia pestis (возбудитель чумы), а где наивность?).
Все, что будет написано в дальнейшем, будет касаться дикой микрофлоры, если не будет указано иное.
2. Что мы понимаем под антимикробной активностью препарата.
Казалось бы, вопрос очень простой – открываем аннотацию к любому антибиотику, и там все подробно написано. Но все не так просто.
Как определяется антимикробная активность? Правильно – в чашке Петри, на которой в присутствии дисков с антимикробными препаратами (или в жидкой питательной среде с разными концентрациями антибиотиков) засевают изучаемую культуру и смотрят, вырастет ли она вообще (тогда говорят о чувствительности к данному препарату), а если вырастет, то в каком количестве (те самые пресловутые один, два или три креста), в результате чего микроб будет объявлен умеренно чувствительным или полностью резистентным. В более продвинутых случаях детекцию антибиотикочувствительности проводят в автоматических анализаторах с определением минимальных подавляющих концентраций возбудителя (MIC или МПК возбудителя). И в этом кроется главная заковыка – все эти чашки и анализаторы не являются живым человеком, а мы даже близко не чашки Петри. В организме имеется великое множество ферментных систем и естественных барьеров, за которые умеют прятаться возбудители и куда не могут пробиться антибиотики. Кроме того, в чашке и анализаторе можно создать совершенно убийственную для микроба среду, а если то же самое повторить с пациентом, пациент может кончиться намного быстрее, чем кончится микроб (об этом мы поговорим в главе «Безопасность»). Давайте примем за аксиому, что то, что написано в аннотации, – это то, что произошло исключительно в чашках и анализаторах, но чаще всего не имеет никакой клинической значимости, то есть по описанному в аннотации антимикробному спектру ориентироваться нельзя, нужна клиническая эффективность.
Кроме того, достаточно регулярно появляются публикации о том, что какой-то пытливый ум провел очередной эксперимент с каким-нибудь НПВС или антиконвульсантом, или еще чем-нибудь совершенно не антимикробным: замешав его в питательную среду, попытался вырастить какой-нибудь микроб, и тот не вырос. И так мы получаем очередную «сенсацию». А сенсация ли это? Конечно, нет. Напомню еще раз – человек не чашка Петри, а главной целью антимикробного препарата является микроб, а никак не человек. А теперь представьте, какую концентрацию того же НПВС в теле человека надо будет создать, чтобы некоторое количество микробной популяции хотя бы придавить. И что будет с тушкой этого человека после этого, так как первоначальная точка приложения данной группы препаратов отнюдь не патогенная флора, не говоря уж о том, что и спектр действия подобной «терапии» совершенно неясен. Что-то упорно подсказывает, что на фоне подобных экспериментов опыты доктора Менгеле покажутся детским лепетом.
Так на что же мы должны ориентироваться в определении антимикробной активности? Как мы уже договорились выше, говорить будем в основном о дикой микрофлоре, и для нее антимикробная активность является табличным справочным материалом, который можно использовать в качестве шпаргалки на первых порах освоения вопроса. Где же взять эти таблицы? Для начала – это любой качественный справочник по антимикробной терапии с соответствующей вкладкой. Причем любой за последние 10-15 лет, так как принципиально в антимикробных спектрах дикой флоры ничего не поменялось, а введенные в практику новые антибиотики – это препараты настолько глубокого резерва, что без специальных знаний их не то, что использовать, трогать нельзя. Вопросы безопасности АБТ мы обсудим отдельно в соответствующей главе.
Какие справочники мы могли бы посоветовать? Во-первых, это издания Смоленского НИИ антимикробной химиотрерапии, которые каждый год реализуются в рамках Конгресса МАКМАХ в Москве в мае. Во-вторых, это в том числе переведенные на русский язык Сэнфордские справочники антимикробной терапии и, отдельно для педиатров, – «Антимикробная терапия у детей по Нельсону». Все они карманного формата и помимо антимикробных спектров содержат огромное количество полезной и необходимой для работы информации. Если вы владеете английским на уровне чтения технической литературы, перед вами раскроются такие источники как справочник по антимикробной терапии Хопкинса (отдельные материалы доступны по этой ссылке) и оригинальный Сэнфорд, которые можно установить в свои гаджеты.
3. Каких возбудителей мы будем истреблять?
В обязательном порядке всех абсолютных патогенов (возбудителей чумы, малярии, тифа и далее по списку). Этих представителей микромира в норме в человеке быть не может. А если они есть, да не просто на коже (тогда бы вымерли все хирурги, АиРы и дерматовенерологи), а во внутренних средах организма – это патоген в 95% случаев. Оставшиеся 5% оставим ацинеткам и синегнойкам на так называемую контаминацию/колонизацию, не вызывающую заболевания, но такие состояния надо уметь отличать от истинного заболевания.
Кроме того, меры высшей социальной защиты применяем по отношению к так называемым условным патогенам, то есть тем микробам, которые в местах своего естественного обитания являются нормальными жителями (например, кишечная палочка в кишке выполняет множество полезных функций, начиная с синтеза витамина К), но стоит им выбраться из этой среды туда куда не надо – тут же начинаются грандиозные проблемы (та же E.coli, влетевшая в легкие в процессе аспирации, вызывает тяжелую пневмонию, а попав в мочевыводящие пути не менее тяжелый пиелонефрит).
Для того чтобы понимать, в какой локации какой микроб норма, а какой уже патология, необходимо знать микробиологию на достаточно высоком уровне, чем мы и будем заниматься в дальнейших главах нашего проекта, а именно постигать АБТ через призму микробиологии, а не банальное перечисление групп препаратов и отдельных их представителей (согласитесь, подобных описаний и так в достатке). Но так как для этого потребуется время, а работать надо здесь и сейчас, то вам помогут вышеуказанные справочники, которые содержат главы «Антибиотикотерапия в зависимости от локализации инфекции», где указываются патогенные микробы для конкретных сред и локаций организма, как уже упомянутая E.coli в бронхоальвеолярном лаваже.
4. Виды антимикробной терапии
Эмпирическую терапию мы используем ежедневно, назначая антибактериальные препараты и не зная наверняка, какой именно возбудитель вызвал заболевание, но предполагая совершенно определенный спектр возбудителей, вызывающих данную инфекцию в зависимости от жалоб, анамнеза и локализации оной. Так как пациента лечить надо сразу, так как при многих состояниях задержка с назначением адекватной терапии увеличивает летальность в 2-3 раза, не говоря о тяжести течения и осложнениях, то были разработаны соответствующие схемы эмпирической терапии. Это тоже является справочным материалом, и толковая книжка в кармане очень помогает решить проблему. Кроме того, в назначении эмпирической терапии может помочь микробиологическая лаборатория, даже в условиях минимального ее оснащения, просто покрасив мазок по Граму, что занимает максимум час с учетом доставки до места. Это поможет сориентироваться, грамположительный или грамотрицательный микроб вызвал текущую проблему (классический пример – покрасить мазок с патологически измененных миндалин и увидеть стрептококк), и назначить антимикробный препарат с соответствующим спектром активности. Еще одним видом помощников являются экспресс-тесты. Подробнее вопрос обсудим в главе по микробиологической диагностике.
Этиотропную терапию мы используем, когда микробиологическая лаборатория выдает результаты посева и чувствительности к антибиотикам и теперь уже почти точно известно, что вызвало заболевание. Почти – это не оговорка, лаборатория может выдать очень странный результат, и задача врача понимать, пришел ли действительно возбудитель, или контаминат, или вообще артефакт. А еще вопрос в том, как быстро лаборатория выдаст этот результат. Идеальной является ситуация, когда лаборатория оснащена системами автоматической детекции и результат выдается в течение максимум 48 часов, укладываясь в рамки сроков оценки эффективности АБТ и принятия последующих решений. Но чаще всего получается так, что пациент давно выписан или переведен в другое отделение, а результаты только-только прибыли, и в такой ситуации смотрим следующий пункт.
5. Критерии эффективности АБТ
– основываются на субъективном мнении врача и клинических критериях.
К клиническим критериям улучшения состояния относятся:
- Уменьшение ЧСС
- Нормализация нервно-психического статуса
- Уменьшение болевых ощущений
- Уменьшение напряжения брюшной стенки
- Возможность приема пищи
- Появление чувства голода
- Появление стула
- Восстановление диуреза
В зависимости от механизма действия препарата, мы используем либо «правило 48 часов», либо «правило 72 часов»
«Правило 48 часов» заключается в том, что мы оцениваем клинические результаты применения антибиотика не ранее, чем через 48 часов, а именно на 3-и сутки. Мы четко должны видеть положительную динамику в виде снижения температуры и интоксикации на фоне приема антибактериальных препаратов. Это правило используется при применении бактерицидных препаратов.
6. Критерии окончания АБТ
Общим правилом для прекращения приема антимикробных препаратов является наступление явного клинического улучшения, определяемого на основании субъективного мнения врача и объективных признаков, таких как:
Читайте также:
